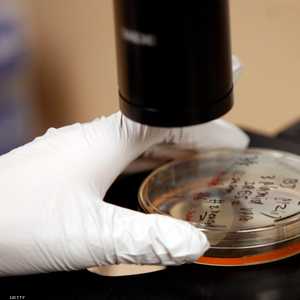
صورة تعبيرية

الألوفيرا.. لماذا سماه المصريون القدماء "نبات الخلود"؟
11:16 - 10 سبتمبر 2019
يعد الألوفيرا إحدى أقوى المعجزات الطبيعية، مع خصائص شفاء لا تعد ولا تحصى تم تقييمها منذ قرون، وبسبب ذلك أطلق عليه المصريون القدماء اسم "نبات الخلود" ، بينما أشار إليه الأميركيون الأصليون باسم "عصا السماء".
ويستخدم هذا النبات المعجزة بشكل شائع في الوقت الحاضر أيضا، لكن يجب أن تعرف أن استخدامه لا يقتصر على الطب فقط في علاج الجروح والخدوش والحروق، وإنما أيضا يمكن تناوله لتحسين الصحة العامة.
فصبار الألوفيرا يحتوي على خصائص مضادة للجراثيم وللفيروسات، كما يعمل على تطهير الجسم وتعزيز الجهاز المناعي.
ويقول موقع "بوريدباندا" إن الإنزيمات الموجودة في الألوفيرا تحلل البروتينات، التي نتناولها إلى أحماض أمينية، كما تحول الإنزيمات إلى وقود لكل خلية في الجسم، مما يمكّن الخلايا من العمل بشكل صحيح.
ويحفز إنزيم براديكيناز الموجود في الصبار نظام المناعة، كما يقضي على الالتهابات، في حين أنه يساعد الصبار في منع الأمراض وقتل البكتيريا وحماية وظيفة أغشية الخلايا.
كما يعد الزنك أيضا مكونًا مهما في الألوفيرا، مما يجعله مصدرا رائعا لمكافحة تراجع معدلاته في الجسم، لأنه ضروري للحفاظ على المناعة.
فالزنك مكون رئيسي لعدد كبير من أجهزة استقبال الهرمونات والبروتينات، التي تساهم في مزاج صحي متوازن ووظيفة مناعية.
وفي السياق، يحتوي الألوفيرا على أكثر من 200 من المكونات النشطة بيولوجيا مثل المعادن والفيتامينات والسكريات والإنزيمات والأحماض الأمينية.
وبشكل عام تعزز معادن الألوفيرا، مثل الزنك والحديد والبوتاسيوم والنحاس والكالسيوم والمغنيسيوم والكروم والسيلينيوم والصوديوم مسارات التمثيل الغذائي.
وعلاوة على ذلك، فهو يحتوي على نسبة عالية من الإنزيمات الهامة مثل الأميليز والليباز والتي يمكن أن تساعد على الهضم عن طريق تحطيم جزيئات الدهون والسكر.